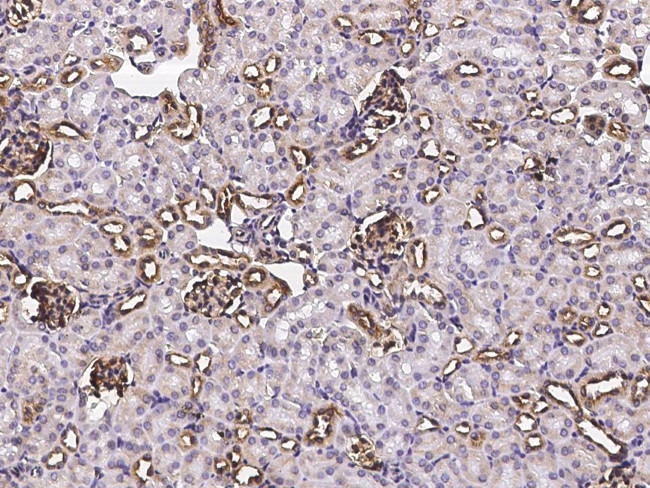
CD59 Antibody in Immunohistochemistry (Paraffin) (IHC (P))

Search
Invitrogen
CD59 Polyclonal Antibody
{{$productOrderCtrl.translations['antibody.pdp.commerceCard.promotion.promotions']}}
{{$productOrderCtrl.translations['antibody.pdp.commerceCard.promotion.viewpromo']}}
{{$productOrderCtrl.translations['antibody.pdp.commerceCard.promotion.promocode']}}: {{promo.promoCode}} {{promo.promoTitle}} {{promo.promoDescription}}. {{$productOrderCtrl.translations['antibody.pdp.commerceCard.promotion.learnmore']}}
产品信息
PA5-81341
宿主/亚型
分类
类型
抗原
偶联物
形式
浓度
规格
保存条件
运输条件
RRID
产品详细信息
This product is preservative free. It is recommended to add sodium azide to avoid contamination (final concentration 0.05%-0.1%).
This antibody has specificity for Mouse CD59a/Protectin.
靶标信息
CD59 (Protectin) is a small (18-20 kDa) GPI-anchored ubiquitously expressed inhibitor of the membrane attack complex (MAC). CD59 is the key regulator that preserves the autologous cells from terminal effector mechanism of the complement cascade. CD59 also associates with C5b-8 complex and counteracts appropriate formation of cytolytic pore within the plasma membrane. Further, CD59 is a low-affinity ligand of human CD2, causes T cell costimulation, and is involved in lymphocyte signal transduction. CD59 is a potent inhibitor of the complement membrane attack complex, whereby it binds complement C8 and/or C9 during the assembly of this complex, thereby inhibiting the incorporation of multiple copies of C9 into the complex, which is necessary for osmolytic pore formation. Mutations in this gene cause CD59 deficiency, a disease involving hemolytic anemia, thrombosis, and cerebral infarction. Multiple alternatively spliced transcript variants of CD59 have been identified.
仅用于科研。不用于诊断过程。未经明确授权不得转售。